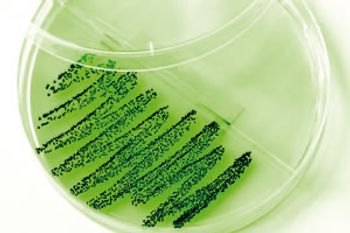
Bacteria-794907-1408597487016.jpg

The Column
A group of scientists in Austria 1 have developed and characterised a method for the detection of S. pneumoniae and H. influenzae in the upper respiratory tract by analysing breath samples of patients.

The Column
A group of scientists in Austria 1 have developed and characterised a method for the detection of S. pneumoniae and H. influenzae in the upper respiratory tract by analysing breath samples of patients.

The Column
Fingerprint analysis has been a standard method for forensic analysis and is used to identify suspects at the scene of a crime. Recent advances in next-generation DNA sequencing technology have revolutionized the criminal justice system and has downgraded the importance of fingerprint analysis. However, the positioning of DNA material can be circumstantial in some cases and this is where recent advances in analytical chemistry instrumentation can enhance the power of fingerprint analysis.

The Column
"Dragon's Blood"(DB) has become increasingly popular in Europe and the USA this year. Marketed as an anti-ageing compound within cosmetics, DB is a deep red resin secreted from the fruit of the dragon tree species, Daemonorops draco. Scientists in China 2 believe they have identified two novel biomarkers that could be used in the QC of DB.

The Column
Jenny Button, Product Specialist at LGC Standards, UK, discusses some commonly reported errors in the use of reference materials and how they can be avoided.

The Column
John Hinshaw offers his insights into how the current helium shortage will affect gas chromatographers and answers some concerns of The Column readers selected from the CHROMacademy Forum.

The Column
Traditionally, measuring the mobility of proteins and nanoparticles has been a challenging task. An effective measurement method traditionally used is phase analysis light scattering (PALS), a technique based on interfering laser light scattered from a sample solution. However, it has been associated with two important shortcomings. Massively Parallel Phase Analysis Light Scattering (MP-PALS) has emerged as a viable alternative to the conventional PALS method.

The Column
Market profile of dissolution testing, a mandatory test for the physical evaluation of drugs that are in a solid dosage form such as capsules, tablets, ointments and creams.
The Column
Antibiotics are used frequently and there has been a corresponding growth in antibiotic-resistant bacterial strains, such as MRSA (multi resistant strain antibiotics). This resistance is placing pressure on healthcare systems worldwide with numerous government agencies, including the World Health Organization (WHO), campaigning to reduce the use of antibiotics. There is now an emerging research focus on the development of plant-based anti-microbial agents that could be used for non-medicinal purposes; specifically of interest is the use of antimicrobials in the preservation of foodstuffs.